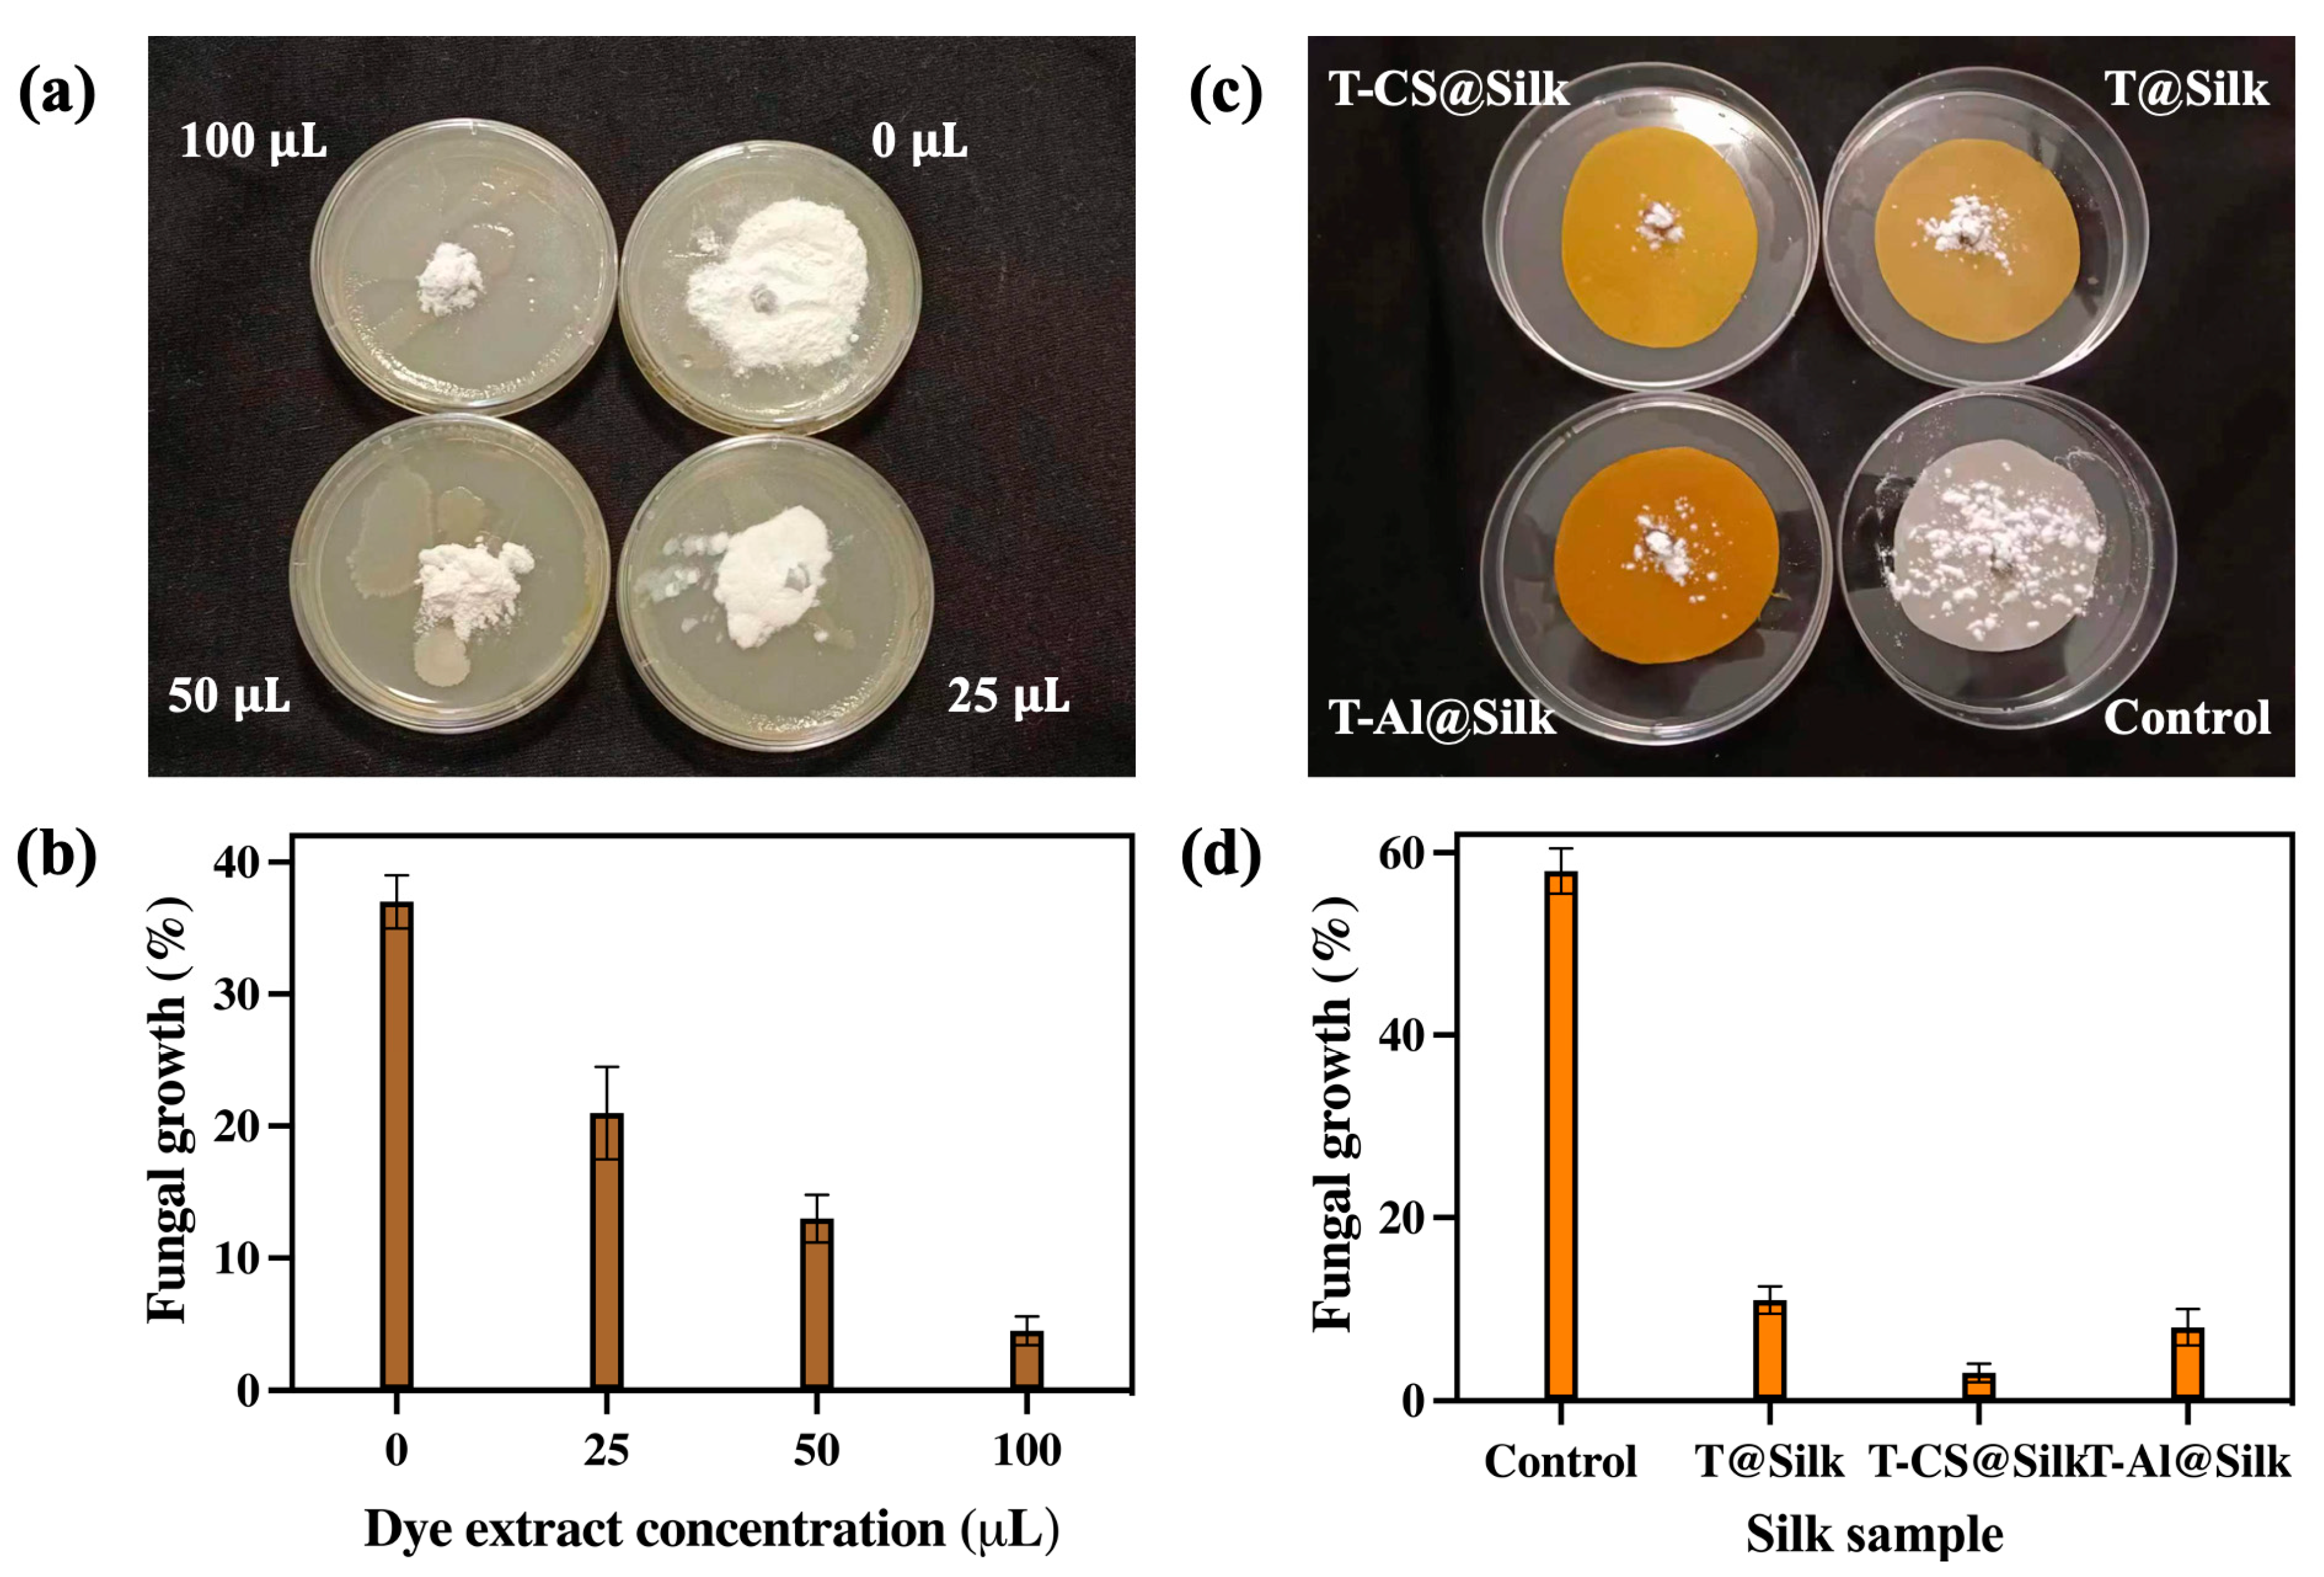

Bioactive Silk Revolution: Harnessing Curcuminoid Dye and Chitosan for Superior Antimicrobial Defence and UV Shielding
Abstract
1. Introduction
2. Materials and Methods
2.1. Materials
2.2. Methods
2.2.1. Extraction of Turmeric Dye
2.2.2. Mordanting for Silk
2.2.3. Dyeing for Silk
2.3. Characterization Techniques
2.3.1. Liquid Chromatography—Mass Spectrometry (LC-MS)
2.3.2. Silk Characterization
2.3.3. Colouring Property
2.3.4. Air Permeability
2.4. Colour Fastness Analysis
2.5. Investigation of Functional Properties of Silk
2.5.1. Antibacterial Test
2.5.2. Antifungal Test
2.5.3. UV Protection Test
3. Results and Discussion
3.1. Characterizations of Turmeric Dye Extract
3.2. Silk Characterizations
3.3. Colouration and Fastness of Silk
3.4. Functional Performances of Silk
3.4.1. Antibacterial Activity
3.4.2. Antifungal Activity
3.4.3. UV-Protective Activity
4. Conclusions and Perspectives
Future Perspectives
Author Contributions
Funding
Institutional Review Board Statement
Informed Consent Statement
Data Availability Statement
Acknowledgments
Conflicts of Interest
References
- Forster, V.; Vettese Forster, S.; Christie, R.M. The Significance of the Introduction of Synthetic Dyes in the Mid 19th Century on the Democratisation of Western Fashion. J. Intern. Colour. Assoc. 2013, 11, 1–17. [Google Scholar]
- Islam, T.; Repon, M.R.; Islam, T.; Sarwar, Z.; Rahman, M.M. Impact of Textile Dyes on Health and Ecosystem: A Review of Structure, Causes, and Potential Solutions. Environ. Sci. Pollut. Res. 2023, 30, 9207–9242. [Google Scholar] [CrossRef] [PubMed]
- Khan, W.U.; Ahmed, S.; Dhoble, Y.; Madhav, S. A Critical Review of Hazardous Waste Generation from Textile Industries and Associated Ecological Impacts. J. Indian Chem. Soc. 2023, 100, 100829. [Google Scholar] [CrossRef]
- Al-Tohamy, R.; Ali, S.S.; Li, F.; Okasha, K.M.; Mahmoud, Y.A.G.; Elsamahy, T.; Jiao, H.; Fu, Y.; Sun, J. A Critical Review on the Treatment of Dye-Containing Wastewater: Ecotoxicological and Health Concerns of Textile Dyes and Possible Remediation Approaches for Environmental Safety. Ecotoxicol. Environ. Saf. 2022, 231, 113160. [Google Scholar] [CrossRef]
- Li, N.; Wang, Q.; Zhou, J.; Li, S.; Liu, J.; Chen, H. Insight into the Progress on Natural Dyes: Sources, Structural Features, Health Effects, Challenges, and Potential. Molecules 2022, 27, 3291. [Google Scholar] [CrossRef] [PubMed]
- Dulo, B.; Phan, K.; Githaiga, J.; Raes, K.; De Meester, S. Natural Quinone Dyes: A Review on Structure, Extraction Techniques, Analysis and Application Potential. Waste Biomass Valoriz. 2021, 12, 6339–6374. [Google Scholar] [CrossRef]
- Câmara, J.S.; Locatelli, M.; Pereira, J.A.M.; Oliveira, H.; Arlorio, M.; Fernandes, I.; Perestrelo, R.; Freitas, V.; Bordiga, M. Behind the Scenes of Anthocyanins—From the Health Benefits to Potential Applications in Food, Pharmaceutical and Cosmetic Fields. Nutrients 2022, 14, 5133. [Google Scholar] [CrossRef]
- Nabi, B.G.; Mukhtar, K.; Ahmed, W.; Manzoor, M.F.; Ranjha, M.M.A.N.; Kieliszek, M.; Bhat, Z.F.; Aadil, R.M. Natural Pigments: Anthocyanins, Carotenoids, Chlorophylls, and Betalains as Colorants in Food Products. Food Biosci. 2023, 52, 102403. [Google Scholar] [CrossRef]
- Mocquard, J.; Le Lamer, A.C.; Fabre, P.L.; Mathieu, C.; Chastrette, C.; Vitrai, A.; Vandenbossche, V. Indigo Dyeing from Isatis tinctoria L.: From Medieval to Modern Use. Dyes. Pigm. 2022, 207, 110675. [Google Scholar] [CrossRef]
- Carreón-Hidalgo, J.P.; Franco-Vásquez, D.C.; Gómez-Linton, D.R.; Pérez-Flores, L.J. Betalain Plant Sources, Biosynthesis, Extraction, Stability Enhancement Methods, Bioactivity, and Applications. Food Res. Intern. 2022, 151, 110821. [Google Scholar] [CrossRef]
- Kamboj, A.; Jose, S.; Singh, A. Antimicrobial Activity of Natural Dyes—A Comprehensive Review. J. Nat. Fibers 2022, 19, 5380–5394. [Google Scholar] [CrossRef]
- Gulati, R.; Sharma, S.; Sharma, R.K. Antimicrobial Textile: Recent Developments and Functional Perspective. Polym. Bull. 2022, 79, 5747–5771. [Google Scholar] [CrossRef] [PubMed]
- Marino, A.; Battaglini, M.; Moles, N.; Ciofani, G. Natural Antioxidant Compounds as Potential Pharmaceutical Tools against Neurodegenerative Diseases. Acs Omega 2022, 7, 25974–25990. [Google Scholar] [CrossRef] [PubMed]
- Rahaman, M.M.; Hossain, R.; Herrera-Bravo, J.; Islam, M.T.; Atolani, O.; Adeyemi, O.S.; Owolodun, O.A.; Kambizi, L.; Daştan, S.D.; Calina, D.; et al. Natural Antioxidants from Some Fruits, Seeds, Foods, Natural Products, and Associated Health Benefits: An Update. Food Sci. Nutr. 2023, 11, 1657–1670. [Google Scholar] [CrossRef] [PubMed]
- Fernandes, A.; Rodrigues, P.M.; Pintado, M.; Tavaria, F.K. A Systematic Review of Natural Products for Skin Applications: Targeting Inflammation, Wound Healing, and Photo-Aging. Phytomedicine 2023, 115, 154824. [Google Scholar] [CrossRef]
- Uddin, M.A.; Rahman, M.M.; Haque, A.N.M.A.; Smriti, S.A.; Datta, E.; Farzana, N.; Chowdhury, S.; Haider, J.; Muhammad Sayem, A.S. Textile Colouration with Natural Colourants: A Review. J. Clean. Prod. 2022, 349, 131489. [Google Scholar] [CrossRef]
- Najmi, A.; Javed, S.A.; Al Bratty, M.; Alhazmi, H.A. Modern Approaches in the Discovery and Development of Plant-Based Natural Products and Their Analogues as Potential Therapeutic Agents. Molecules 2022, 27, 349. [Google Scholar] [CrossRef]
- Lama-Muñoz, A.; Contreras, M.d.M. Extraction Systems and Analytical Techniques for Food Phenolic Compounds: A Review. Foods 2022, 11, 3671. [Google Scholar] [CrossRef]
- Ricci, A.; Olejar, K.J.; Parpinello, G.P.; Kilmartin, P.A.; Versari, A. Application of Fourier Transform Infrared (FTIR) Spectroscopy in the Characterization of Tannins. Appl. Spectrosc. Rev. 2015, 50, 407–442. [Google Scholar] [CrossRef]
- Jehlička, J.; Edwards, H.G.M.; Oren, A. Analysis of Brown, Violet and Blue Pigments of Microorganisms by Raman Spectroscopy. Trends Analyt. Chem. 2022, 146, 116501. [Google Scholar] [CrossRef]
- Do, K.L.; Su, M.; Zhao, F. From Historical Dye to Bio-Colourant: Processing, Identification in Historical Textiles and Potential Applications of Anthraquinone-Based Morindone. Dyes Pigm. 2022, 205, 110482. [Google Scholar] [CrossRef]
- Do, K.L.; Mushtaq, A.; Zhao, F.; Su, M. Alizarin Old and New: Extraction Techniques for Colouration, Advances in Detection Methods for Historical Textiles, and Novel Applications as a Functional Dye. Color. Technol. 2024, 140, 5–29. [Google Scholar] [CrossRef]
- Do, K.L.; Mushtaq, A.; Liu, J.; Zhao, F.; Su, M. Unveiling the Use of Natural and Early Synthetic Dyes in Indonesian Historical Silk Textiles. Fibers Polym. 2024, 25, 2233–2244. [Google Scholar] [CrossRef]
- Shah, M.; Murad, W.; Mubin, S.; Ullah, O.; Rehman, N.U.; Rahman, M.H. Multiple Health Benefits of Curcumin and Its Therapeutic Potential. Environ. Sci. Pollut. Res. 2022, 29, 43732–43744. [Google Scholar] [CrossRef]
- Echegaray, N.; Guzel, N.; Kumar, M.; Guzel, M.; Hassoun, A.; Lorenzo, J.M. Recent Advancements in Natural Colorants and Their Application as Coloring in Food and in Intelligent Food Packaging. Food. Chem. 2023, 404, 134453. [Google Scholar] [CrossRef] [PubMed]
- Repon, M.R.; Dev, B.; Rahman, M.A.; Jurkonienė, S.; Haji, A.; Alim, M.A.; Kumpikaitė, E. Textile Dyeing Using Natural Mordants and Dyes: A Review. Environ. Chem. Lett. 2024, 22, 1473–1520. [Google Scholar] [CrossRef]
- Quispe, C.; Herrera-Bravo, J.; Javed, Z.; Khan, K.; Raza, S.; Gulsunoglu-Konuskan, Z.; Daştan, S.D.; Sytar, O.; Martorell, M.; Sharifi-Rad, J.; et al. Therapeutic Applications of Curcumin in Diabetes: A Review and Perspective. Biomed. Res. Int. 2022, 2022, 1375892. [Google Scholar] [CrossRef] [PubMed]
- Weng, W.; Goel, A. Curcumin and Colorectal Cancer: An Update and Current Perspective on This Natural Medicine. Semin. Cancer. Biol. 2022, 80, 73–86. [Google Scholar] [CrossRef]
- Yoon, H.J.; Zhang, X.; Kang, M.G.; Kim, G.J.; Shin, S.Y.; Baek, S.H.; Lee, B.N.; Hong, S.J.; Kim, J.T.; Hong, K.; et al. Cytotoxicity Evaluation of Turmeric Extract Incorporated Oil-in-Water Nanoemulsion. Int. J. Mol. Sci. 2018, 19, 280. [Google Scholar] [CrossRef]
- Cerveira, M.M.; Vianna, H.S.; Ferrer, E.M.K.; da Rosa, B.N.; de Pereira, C.M.P.; Baldissera, M.D.; Lopes, L.Q.S.; Rech, V.C.; Giongo, J.L.; de Almeida Vaucher, R. Bioprospection of Novel Synthetic Monocurcuminoids: Antioxidant, Antimicrobial, and in Vitro Cytotoxic Activities. Biomed. Pharmacother. 2021, 133, 111052. [Google Scholar] [CrossRef]
- Alves, C.; Ribeiro, A.; Pinto, E.; Santos, J.; Soares, G. Exploring Z-Tyr-Phe-OH-Based Hydrogels Loaded with Curcumin for the Development of Dressings for Wound Healing. J. Drug. Deliv. Sci. Technol. 2022, 73, 103484. [Google Scholar] [CrossRef]
- Urošević, M.; Nikolić, L.; Gajić, I.; Nikolić, V.; Dinić, A.; Miljković, V. Curcumin: Biological Activities and Modern Pharmaceutical Forms. Antibiotics 2022, 11, 135. [Google Scholar] [CrossRef] [PubMed]
- Gul, P.; Bakht, J. Antimicrobial Activity of Turmeric Extract and Its Potential Use in Food Industry. J. Food. Sci. Technol. 2015, 52, 2272–2279. [Google Scholar] [CrossRef] [PubMed]
- Teow, S.Y.; Liew, K.; Ali, S.A.; Khoo, A.S.B.; Peh, S.C. Antibacterial Action of Curcumin against Staphylococcus aureus: A Brief Review. J. Trop. Med. 2016, 2016, 2853045. [Google Scholar] [CrossRef] [PubMed]
- Nasaj, M.; Chehelgerdi, M.; Asghari, B.; Ahmadieh-Yazdi, A.; Asgari, M.; Kabiri-Samani, S.; Sharifi, E.; Arabestani, M. Factors Influencing the Antimicrobial Mechanism of Chitosan Action and Its Derivatives: A Review. Int. J. Biol. Macromol. 2024, 277, 134321. [Google Scholar] [CrossRef]
- Abd El-Hack, M.E.; El-Saadony, M.T.; Shafi, M.E.; Zabermawi, N.M.; Arif, M.; Batiha, G.E.; Khafaga, A.F.; Abd El-Hakim, Y.M.; Al-Sagheer, A.A. Antimicrobial and Antioxidant Properties of Chitosan and Its Derivatives and Their Applications: A Review. Int. J. Biol. Macromol. 2020, 164, 2726–2744. [Google Scholar] [CrossRef]
- Fang, J.; Meng, C.; Wang, Y.; Yang, Y.; Han, L.; Wang, S.; Zhang, G.; Xu, Z.; Min, J. Eco-Dyeing and Functional Finishing of Cotton Fabric by Natural Dye Derived from Lotus Seedpod Waste with Chitosan-Assistance. Fibers Polym. 2023, 24, 1367–1377. [Google Scholar] [CrossRef]
- Rahman, M.M.; Koh, J.; Hong, K.H. Sustainable Chitosan Biomordant Dyeing and Functionalization of Cotton Fabrics Using Pomegranate Rind and Onion Peel Extracts. J. Nat. Fibers 2023, 21, 2290856. [Google Scholar] [CrossRef]
- Do, K.L.; Su, M.; Mushtaq, A.; Zhao, F. Dyeing of Silk with Natural Lac Dye from Laccifer Lacca Kerr. and Evaluation of Antibacterial and UV-Protective Properties. Fibers Polym. 2023, 24, 2773–2783. [Google Scholar] [CrossRef]
- Do, K.L.; Mushtaq, A.; Ahsan, T.; Yousaf, M.; Zhao, F.; Su, M. Flavonoid-Based Yellow Dye Extract from Safflower (Carthamus tinctorius L.) Combined with Chitosan for Anti-Bacterial and Ultraviolet-Protective Functionalisation of Silk. Color. Technol. 2024, 140, 900–912. [Google Scholar] [CrossRef]
- ASTM D737-18; Standard test method for air permeability of textile fabrics. American Society for Testing and Materials: West Conshohocken, PA, USA, 2023.
- ISO 105-C06; Textiles—Tests for colour fastness—Part C06: Colour fastness to domestic and commercial laundering. International Standard Organization: Geneva, Switzerland, 2010.
- ISO 105-X12:2016; Textiles—Tests for colour fastness—Part X12: Colour fastness to rubbing. International Standard Organization: Geneva, Switzerland, 2016.
- ISO 105-B02:2013; Textiles—Tests for colour fastness—Part B02: Colour fastness to artificial light: Xenon arc fading lamp test. International Standard Organization: Geneva, Switzerland, 2013.
- ISO 105-A02:1993; Textiles—Tests for colour fastness—Part A02: Grey scale for assessing change in colour. International Standard Organization: Geneva, Switzerland, 1993.
- Schuessler, Z. Delta E 101. Available online: http://zschuessler.github.io/DeltaE/learn/ (accessed on 31 October 2024).
- Hou, J.; Yang, Y.; Yu, D.G.; Chen, Z.; Wang, K.; Liu, Y.; Williams, G.R. Multifunctional Fabrics Finished Using Electrosprayed Hybrid Janus Particles Containing Nanocatalysts. Chem. Eng. J. 2021, 411, 128474. [Google Scholar] [CrossRef]
- Bellotti, N.; Salvatore, L.; Deyá, C.; Del Panno, M.T.; del Amo, B.; Romagnoli, R. The Application of Bioactive Compounds from the Food Industry to Control Mold Growth in Indoor Waterborne Coatings. Colloids. Surf. B 2013, 104, 140–144. [Google Scholar] [CrossRef]
- AATCC 183:2020; Transmittance or blocking of erthemally weighted ultraviolet radiation through fabrics. The American Association of Textile Chemists and Colorists: Durham, NC, USA, 2020.
- Jiang, H.; Somogyi, Á.; Jacobsen, N.E.; Timmermann, B.N.; Gang, D.R. Analysis of Curcuminoids by Positive and Negative Electrospray Ionization and Tandem Mass Spectrometry. Rapid Commun. Mass Spectrom. 2006, 20, 1001–1012. [Google Scholar] [CrossRef] [PubMed]
- Zhang, Y.; Shi, S.; Chen, X.; Peng, M. Functionalized Magnetic Nanoparticles Coupled with Mass Spectrometry for Screening and Identification of Cyclooxygenase-1 Inhibitors from Natural Products. J. Chromatogr. B Analyt. Technol. Biomed. Life Sci. 2014, 960, 126–132. [Google Scholar] [CrossRef] [PubMed]
- Rohaeti, E.; Rafi, M.; Syafitri, U.D.; Heryanto, R. Fourier Transform Infrared Spectroscopy Combined with Chemometrics for Discrimination of Curcuma longa, Curcuma xanthorrhiza and Zingiber cassumunar. Spectrochim. Acta. A Mol. Biomol. Spectrosc. 2015, 137, 1244–1249. [Google Scholar] [CrossRef] [PubMed]
- Wulandari, R.; Sudjadi; Martono, S.; Rohman, A. Liquid Chromatography and Fourier Transform Infrared Spectroscopy for Quantitative Analysis of Individual and Total Curcuminoid in Curcuma longa Extract. J. Appl. Pharm. Sci. 2018, 8, 107–113. [Google Scholar]
- Habib, N.; Ali, A.; Adeel, S.; Fazal-ur-Rehman; Aftab, M.; Inayat, A. Assessment of Wild Turmeric–Based Eco-Friendly Yellow Natural Bio-Colorant for Dyeing of Wool Fabric. Environ. Sci. Pollut. Res. 2023, 30, 4570–4581. [Google Scholar] [CrossRef]
- Rahman, M.M.; Kim, M.; Youm, K.; Kumar, S.; Koh, J.; Hong, K.H. Sustainable One-Bath Natural Dyeing of Cotton Fabric Using Turmeric Root Extract and Chitosan Biomordant. J. Clean. Prod. 2023, 382, 135303. [Google Scholar] [CrossRef]
- Sahne, F.; Mohammadi, M.; Najafpour, G.D.; Moghadamnia, A.A. Enzyme-Assisted Ionic Liquid Extraction of Bioactive Compound from Turmeric (Curcuma longa L.): Isolation, Purification and Analysis of Curcumin. Ind. Crops Prod. 2017, 95, 686–694. [Google Scholar] [CrossRef]
- Deveoglu, O.; Karadag, R.; Spinella, A.; Guzel, E.T. Examination of Dyeing Properties on Silk of Some Flavonoids by Spectroscopic Techniques. J. Nat. Fibers 2021, 18, 238–249. [Google Scholar] [CrossRef]
- Raza Naqvi, S.A.; Kaif ul-Wara; Adeel, S.; Mia, R.; Hosseinnezhad, M.; Rather, L.J.; Imran, M. Modern Ecofriendly Approach for Extraction of Luteolin Natural Dye from Weld for Silk Fabric and Wool Yarn Dyeing. Sustain. Chem. Pharm. 2024, 39, 101554. [Google Scholar] [CrossRef]
- Jia, W.; Wang, Q.; Fan, X.; Dong, A.; Yu, Y.; Wang, P. Mechanism and Analysis of Laccase-Mediated Coloration of Silk Fabrics. Fibers Polym. 2018, 19, 868–876. [Google Scholar] [CrossRef]
- Rani, S.; Kadam, V.; Rose, N.M.; Jose, S.; Yadav, S.; Shakyawar, D.B. Wheat Starch, Gum Arabic and Chitosan Biopolymer Treatment of Wool Fabric for Improved Shrink Resistance Finishing. Int. J. Biol. Macromol. 2020, 163, 1044–1052. [Google Scholar] [CrossRef] [PubMed]
- Yao, T.; Jiang, T.; Pan, D.; Xu, Z.-X.; Zhou, P. Effect of Al(III) and Curcumin on Silk Fibroin Conformation and Aggregation Morphology. Rsc. Adv. 2014, 4, 40273–40280. [Google Scholar] [CrossRef]
- Chen, W.; Ye, K.; Zhu, X.; Zhang, H.; Si, R.; Chen, J.; Chen, Z.; Song, K.; Yu, Z.; Han, B. Actinomycin X2, an Antimicrobial Depsipeptide from Marine-Derived Streptomyces Cyaneofuscatus Applied as a Good Natural Dye for Silk Fabric. Mar. Drugs 2022, 20, 16. [Google Scholar] [CrossRef]
- Kumar Dan, A.; Biswal, B.; Das, M.; Parida, S.; Kumar Parhi, P.; Das, D. Aqueous and Chemical Extraction of Saponin of Acacia Concinna (Willd.) Dc.: An Effective Bio-Surfactant Solution to Extract Silk Fibroin from Muga Silk Cocoons. J. Mol. Liq. 2022, 360, 119547. [Google Scholar] [CrossRef]
- Teli, M.D.; Pandit, P. Application of Sterculia Foetida Fruit Shell Waste Biomolecules on Silk for Aesthetic and Wellness Properties. Fibers Polym. 2018, 19, 41–54. [Google Scholar] [CrossRef]
- Yasukawa, A.; Fukuyama, M.; Iwai, K. Dyeing Silk and Cotton Fabrics Using Fuji Apple Peel and the Properties of the Dyed Fabrics. Text. Res. J. 2021, 91, 2669–2681. [Google Scholar] [CrossRef]
- Borah, S.; Bhuyan, P.M.; Sarma, B.; Hazarika, S.; Gogoi, A.; Gogoi, P. Sustainable Dyeing of Mulberry Silk Fabric Using Extracts of Green Tea (Camellia sinensis): Extraction, Mordanting, Dyed Silk Fabric Properties and Silk-Dye Interaction Mechanism. Ind. Crops Prod. 2023, 205, 117517. [Google Scholar] [CrossRef]
- Jaya Prakash, N.; Shanmugarajan, D.; Kandasubramanian, B.; Khot, P.; Kodam, K. Biodegradable Silk-Curcumin Composite for Sustained Drug Release and Visual Wound Monitoring. Mater. Today Chem. 2023, 27, 101289. [Google Scholar] [CrossRef]
- Zhou, Y.; Zhang, J.; Tang, R.C.; Zhang, J. Simultaneous Dyeing and Functionalization of Silk with Three Natural Yellow Dyes. Ind. Crops Prod. 2015, 64, 224–232. [Google Scholar] [CrossRef]
- del Hoyo-Meléndez, J.M.; Mecklenburg, M.F. Micro-Fading Spectrometry: A Tool for Real-Time Assessment of the Light-Fastness of Dye/Textile Systems. Fibers Polym. 2012, 13, 1079–1085. [Google Scholar] [CrossRef]
- Shukla, D.; Vankar, P.S. Curcuma Dye with Modified Treatment Using Chitosan for Superior Fastness. Fibers Polym. 2018, 19, 1913–1920. [Google Scholar] [CrossRef]
- Chimprasit, A.; Hannongbua, S.; Saparpakorn, P. Adsorption Study of Lac Dyes with Chitosan Coated on Silk Fibroin Using Molecular Dynamics Simulations. J. Mol. Graph. Model. 2021, 106, 107934. [Google Scholar] [CrossRef]
- Manian, A.P.; Paul, R.; Bechtold, T. Metal Mordanting in Dyeing with Natural Colourants. Color. Technol. 2016, 132, 107–113. [Google Scholar] [CrossRef]
- Shakeri, A.; Panahi, Y.; Johnston, T.P.; Sahebkar, A. Biological Properties of Metal Complexes of Curcumin. Bio. Fact. 2019, 45, 304–317. [Google Scholar] [CrossRef]
- Ghoreishian, S.M.; Maleknia, L.; Mirzapour, H.; Norouzi, M. Antibacterial Properties and Color Fastness of Silk Fabric Dyed with Turmeric Extract. Fibers Polym. 2013, 14, 201–207. [Google Scholar] [CrossRef]
- Bide, M. Dyeing. Kirk-Othmer Encyclopedia of Chemical Technology; Wiley: Hoboken, NJ, USA, 2016; Volume 5, pp. 1–115. [Google Scholar] [CrossRef]
- Zheng, D.; Huang, C.; Huang, H.; Zhao, Y.; Khan, M.R.U.; Zhao, H.; Huang, L. Antibacterial Mechanism of Curcumin: A Review. Chem. Biodivers. 2020, 17, e2000171. [Google Scholar] [CrossRef]
- Dai, C.; Lin, J.; Li, H.; Shen, J.; Shen, Z.; Wang, Y.; Velkov, T. The Natural Product Curcumin as an Antibacterial Agent: Current Achievements and Problems. Antioxidants 2022, 11, 459. [Google Scholar] [CrossRef]
- Hatamipour, M.; Ramezani, M.; Tabassi, S.A.S.; Johnston, T.P.; Sahebkar, A. Demethoxycurcumin: A Naturally Occurring Curcumin Analogue for Treating Non-Cancerous Diseases. J. Cell. Physiol. 2019, 234, 19320–19330. [Google Scholar] [CrossRef]
- Khatoon, U.T.; Nageswara Rao, G.V.S.; Mohan, K.M.; Ramanaviciene, A.; Ramanavicius, A. Antibacterial and Antifungal Activity of Silver Nanospheres Synthesized by Tri-Sodium Citrate Assisted Chemical Approach. Vacuum 2017, 146, 259–265. [Google Scholar] [CrossRef]
- Ye, L.; Cao, Z.; Liu, X.; Cui, Z.; Li, Z.; Liang, Y.; Zhu, S.; Wu, S. Noble Metal-Based Nanomaterials as Antibacterial Agents. J. Alloys. Compd. 2022, 904, 164091. [Google Scholar] [CrossRef]
- Hameed, S.; Sharif, S.; Ovais, M.; Xiong, H. Emerging Trends and Future Challenges of Advanced 2D Nanomaterials for Combating Bacterial Resistance. Bioact. Mater. 2024, 38, 225–257. [Google Scholar] [CrossRef]
- Ardean, C.; Davidescu, C.M.; Nemeş, N.S.; Negrea, A.; Ciopec, M.; Duteanu, N.; Negrea, P.; Duda-seiman, D.; Musta, V. Factors Influencing the Antibacterial Activity of Chitosan and Chitosan Modified by Functionalization. Int. J. Mol. Sci. 2021, 22, 7449. [Google Scholar] [CrossRef]
- Ke, C.L.; Deng, F.S.; Chuang, C.Y.; Lin, C.H. Antimicrobial Actions and Applications of Chitosan. Polymers 2021, 13, 904. [Google Scholar] [CrossRef] [PubMed]
- Swoboda, J.G.; Meredith, T.C.; Campbell, J.; Brown, S.; Suzuki, T.; Bollenbach, T.; Malhowski, A.J.; Kishony, R.; Gilmore, M.S.; Walker, S. Discovery of a Small Molecule That Blocks Wall Teichoic Acid Biosynthesis in Staphylococcus aureus. Acs. Chem. Biol. 2009, 4, 875–883. [Google Scholar] [CrossRef] [PubMed]
- Shahmoradi Ghaheh, F.; Mortazavi, S.M.; Alihosseini, F.; Fassihi, A.; Shams Nateri, A.; Abedi, D. Assessment of Antibacterial Activity of Wool Fabrics Dyed with Natural Dyes. J. Clean. Prod. 2014, 72, 139–145. [Google Scholar] [CrossRef]
- Narayana Swamy, V.; Gowda, K.N.; Sudhakar, R. Natural Dye Extracted from Vitex Negundo as a Potential Alternative to Synthetic Dyes for Dyeing of Silk. J. Ins. Eng. India E 2016, 97, 31–38. [Google Scholar] [CrossRef][Green Version]
- Shahid-ul-Islam; Wani, S.A.; Mohammad, F. Imparting Functionality Viz Color, Antioxidant and Antibacterial Properties to Develop Multifunctional Wool with Tectona Grandis Leaves Extract Using Reflectance Spectroscopy. Int. J. Biol. Macromol. 2018, 109, 907–913. [Google Scholar] [CrossRef]
- Hu, Y.; Zhang, J.; Kong, W.; Zhao, G.; Yang, M. Mechanisms of Antifungal and Anti-Aflatoxigenic Properties of Essential Oil Derived from Turmeric (Curcuma longa L.) on Aspergillus flavus. Food. Chem. 2017, 220, 1–8. [Google Scholar] [CrossRef]
- Poznanski, P.; Hameed, A.; Orczyk, W. Chitosan and Chitosan Nanoparticles: Parameters Enhancing Antifungal Activity. Molecules 2023, 28, 2996. [Google Scholar] [CrossRef] [PubMed]

| Sample | Silk Picture | K/S | Colour Coordinates | Fastness | ∆E* | Air Permeability (mm/s) | |||||
|---|---|---|---|---|---|---|---|---|---|---|---|
| L* | a* | b* | L | W | DR | WR | |||||
| T@Silk | ![]() | 12.82 | 75.48 | 1.73 | 75.44 | 3–4 | 2–3 | 2–3 | 2–3 | 4.69 | 554.91 |
| T-CS@Silk | ![]() | 19.70 | 64.34 | 11.46 | 71.70 | 4–5 | 4–5 | 3–4 | 3–4 | 1.26 | 495.41 |
| T-Al@Silk | ![]() | 13.65 | 65.67 | 2.25 | 63.55 | 3–4 | 3–4 | 3–4 | 3–4 | 2.83 | 514.24 |
| Silk Sample | UV Transmittance (%) | UV Blocking (%) | UPF | Ranking | ||
|---|---|---|---|---|---|---|
| UV-A | UV-B | UV-A | UV-B | |||
| Control | 19.72 | 5.64 | 80.28 | 94.36 | 9 | Poor |
| T@Silk | 0.80 | 0.78 | 99.20 | 99.22 | 50+ | Excellent |
| T-CS@Silk | 0.73 | 0.68 | 99.27 | 99.32 | 50+ | Excellent |
| T-Al@Silk | 1.16 | 1.16 | 98.84 | 98.84 | 50+ | Excellent |
Disclaimer/Publisher’s Note: The statements, opinions and data contained in all publications are solely those of the individual author(s) and contributor(s) and not of MDPI and/or the editor(s). MDPI and/or the editor(s) disclaim responsibility for any injury to people or property resulting from any ideas, methods, instructions or products referred to in the content. |
© 2024 by the authors. Licensee MDPI, Basel, Switzerland. This article is an open access article distributed under the terms and conditions of the Creative Commons Attribution (CC BY) license (https://creativecommons.org/licenses/by/4.0/).
Share and Cite
Do, K.L.; Ahsan, T.; Wahab, A.; Tayyab, M.; Yin, X.; Pan, N.; Huang, T.; Mushtaq, A.; Su, M. Bioactive Silk Revolution: Harnessing Curcuminoid Dye and Chitosan for Superior Antimicrobial Defence and UV Shielding. Pharmaceutics 2024, 16, 1510. https://doi.org/10.3390/pharmaceutics16121510
Do KL, Ahsan T, Wahab A, Tayyab M, Yin X, Pan N, Huang T, Mushtaq A, Su M. Bioactive Silk Revolution: Harnessing Curcuminoid Dye and Chitosan for Superior Antimicrobial Defence and UV Shielding. Pharmaceutics. 2024; 16(12):1510. https://doi.org/10.3390/pharmaceutics16121510
Chicago/Turabian StyleDo, Khai Ly, Taswar Ahsan, Abdul Wahab, Muhammad Tayyab, Xinqi Yin, Nengjie Pan, Tao Huang, Asim Mushtaq, and Miao Su. 2024. "Bioactive Silk Revolution: Harnessing Curcuminoid Dye and Chitosan for Superior Antimicrobial Defence and UV Shielding" Pharmaceutics 16, no. 12: 1510. https://doi.org/10.3390/pharmaceutics16121510
APA StyleDo, K. L., Ahsan, T., Wahab, A., Tayyab, M., Yin, X., Pan, N., Huang, T., Mushtaq, A., & Su, M. (2024). Bioactive Silk Revolution: Harnessing Curcuminoid Dye and Chitosan for Superior Antimicrobial Defence and UV Shielding. Pharmaceutics, 16(12), 1510. https://doi.org/10.3390/pharmaceutics16121510




